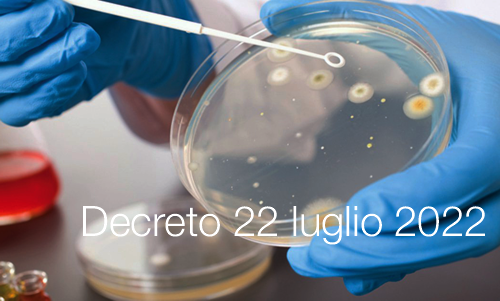
Decreto 22 luglio 2022 Decreto 22 luglio 2022

Decreto 22 luglio 2022
| ID 17527 | | Visite: 2411 | News | Permalink: https://www.certifico.com/id/17527 |
Decreto 22 luglio 2022 / Modifica Decreto PREMAL
Modifica del decreto 7 marzo 2022 concernente il Sistema di segnalazione della malattie infettive (PREMAL)
(GU n.208 del 06.09.2022)
...
Art. 1.
1. L’elenco delle malattie infettive sottoposte a sorveglianza e rilevanti ai sensi dell’art. 2, comma 2, del decreto del Ministro della salute 7 marzo 2022, pubblicato nella Gazzetta Ufficiale della Repubblica italiana - Serie generale - n. 82 del 7 aprile 2022, è contenuto nell’allegato A al presente decreto, di cui costituisce parte integrante.
Art. 2.
1. Il presente decreto aggiorna e sostituisce l’allegato A di cui al decreto del Ministro della salute 7 marzo 2022.
ALLEGATO A
ELENCO MALATTIE INFETTIVE SOTTOPOSTE A SORVEGLIANZA
|
CODICE ICD9-CM - MALATTIA |
|
022 – ANTRACE |
|
088.81 – BORRELIOSI |
|
005.1 – BOTULISMO |
|
023 – BRUCELLOSI |
|
001 – COLERA |
|
007.4 – CRIPTOSPORIDIOSI |
|
061 – DENGUE |
|
110 – DERMATOFITOSI |
|
032 – DIFTERITE |
|
122 – ECHINOCOCCOSI |
|
063 – ENCEFALITE VIRALE DA ZECCHE |
|
064 – ENCEFALITE VIRALE TRASMESSA DA ARTROPODI |
|
070.1 – EPATITE VIRALE A |
|
070.3 – EPATITE VIRALE B |
|
070.51 – 070.54 - EPATITE VIRALE C |
|
070.52 – EPATITE VIRALE D |
|
070.53 – EPATITE VIRALE E |
|
070.9 – EPATITI VIRALI ACUTE ALTRE |
|
066.3 – CHIKUNGUNYA |
|
078.89 – FEBBRE EMORRAGICA VIRALE |
|
060 – FEBBRE GIALLA |
|
083.0 – FEBBRE Q |
|
002 – FEBBRE TIFOIDE E PARATIFOIDE |
|
066.4 – FEBBRE VIRALE WEST NILE |
|
007.1 – GIARDIASI |
|
053 – HERPES ZOSTER |
|
099.5 – INFEZIONE DA CHLAMYDIA |
|
098 – INFEZIONE GONOCOCCICA (BLENORRAGIA) |
|
008.43 – INFEZIONE INTESTINALE DA CAMPYLOBACTER |
|
008.04 – INFEZIONE INTESTINALE DA ESCHERICHIA COLI PRODUTTORE DELLA SHIGA/VEROCITOSSINA (STEC/VTEC) INCLUSA SEU |
|
041.3 – 041.4 INFEZIONI DA ENTEROBATTERI PRODUTTORI DI CARBAPENEMASI (CPE) |
|
008.44 – INFEZIONE INTESTINALE DA YERSINIA ENTEROCOLITICA |
|
003 – INFEZIONI DA SALMONELLA |
|
008.45, 008.61, 008.62, 008.63, 008.67 INFEZIONI – 005.0, 005.2, 005.4, 005.81, 005.89, TOSSINFEZIONI DI ORIGINE ALIMENTARE |
|
487 – INFLUENZA |
|
480.8 – INFLUENZA AVIARIA |
|
030 – LEBBRA |
|
482.84 – LEGIONELLOSI |
|
CODICE ICD9-CM - MALATTIA |
|
085.9 – LEISHMANIOSI CUTANEA |
|
085.0 – LEISHMANIOSI VISCERALE |
|
100 – LEPTOSPIROSI |
|
099.1 – LINFOGRANULOMA VENEREO |
|
027.0 – LISTERIOSI |
|
084.0 – 084.6 - MALARIA |
|
320 – 320.0 - 036.0 – 320.1 MALATTIA BATTERICA INVASIVA |
|
046.1 – MALATTIA DI JAKOB-CREUTZFELDT |
|
047, 047.0, 047.8, 047.9 – MENINGITI VIRALI |
|
031 – MICOBATTERIOSI NON TUBERCOLARE |
|
055 – MORBILLO |
|
072 – PAROTITE EPIDEMICA |
|
132 – PEDICULOSI E FTIRIASI |
|
033 – PERTOSSE |
|
020 – PESTE |
|
045 – POLIOMIELITE ACUTA |
|
073.0 – POLMONITE DA PSITTACOSI |
|
071 – RABBIA |
|
082 – RICKETTSIOSI |
|
056 – ROSOLIA |
|
771.0 – ROSOLIA CONGENITA |
|
647.5 – ROSOLIA IN GRAVIDANZA |
|
133.0 – SCABBIA |
|
034.1 – SCARLATTINA |
|
004 – SHIGELLOSI |
|
480.3 – SINDROME RESPIRATORIA MEDIO ORIENTALE (Mers-CoV) |
|
091 – SIFILIDE |
|
090 – SIFILIDE CONGENITA |
|
037 – TETANO |
|
080 – TIFO [EPIDEMICO] DA PIDOCCHI |
|
130 – TOXOPLASMOSI |
|
771.2 – TOXOPLASMOSI CONGENITA |
|
124 – TRICHINELLOSI |
|
011, 012-012.8, 013-013.9, 014, 015-015.9, 016-016.9, 017- 017.8, 018-018.9 – TUBERCOLOSI |
|
021 – TULAREMIA |
|
050 – VAIOLO |
|
052 – VARICELLA |
|
057.8 VAIOLO DELLE SCIMMIE (Monkeypox) |
|
066.3 – ZIKA |
|
066.3 – ZIKA CONGENITA |
|
000.0 (*) INFEZIONI CORRELATE ALL’ASSISTENZA (ICA) (*) Codice provvisorio non ICD9-CM |
Collegati
Tags: News